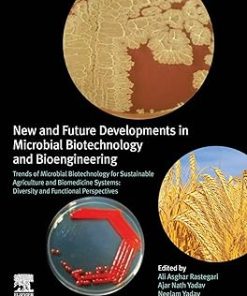
New and Future Developments in Microbial Biotechnology and Bioengineering

Shop
Showing 4861–4869 of 26071 results
Filter by price
Product categories
- Clinical Science (6872)
- Scrub (35)
Showing 16201–16230 of 26071 results
-

Neurosurgery Tricks of the Trade Spine and Peripheral Nerves
Call for Price Quick View Compare -

Neurosurgical Emergencies 3rd Edition
Call for Price Quick View Compare -

Neurosurgical Intensive Care 2nd Edition
Call for Price Quick View Compare -

Neurosurgical Operative Atlas Functional Neurosurgery 3rd Ed
Call for Price Quick View Compare -

Neurosurgical Operative Atlas Vascular Neurosurgery 3rd Ed
Call for Price Quick View Compare -

Neurosurgical Review For Daily Clinical Use and Oral Board Preparation
Call for Price Quick View Compare -

Neurotoxins and Fillers in Facial Esthetic Surgery
Call for Price Quick View Compare -

Neurotrauma
Call for Price Quick View Compare -

Neurotrauma and Critical Care of the Brain
Call for Price Quick View Compare -

Neurotrauma and Critical Care of the Spine
Call for Price Quick View Compare -

Neurovascular Anatomy in Interventional Neuroradiology A Case Based Approach
Call for Price Quick View Compare -

Neurovascular Anatomy in Interventional Neuroradiology A Case Based Approach
Call for Price Quick View Compare -

Neurovascular Anatomy in Interventional Neuroradiology A Case Based Approach
Call for Price Quick View Compare -

Neurovascular Examination The Rapid Evaluation of Stroke Patients Using Ultrasound Waveform Interpretation
Call for Price Quick View Compare -

Never Underestimate a Principal who survived the pandemic
د.إ165.00 Quick View Compare -
Sale!

New A-Level Economics
د.إ635.00Original price was: د.إ635.00.د.إ100.00Current price is: د.إ100.00. Quick View Compare -

New Advances in Heart Failure and Atrial Fibrillation Proceedings of the Mediterranean Cardiology Meeting
Call for Price Quick View Compare -

New and Emerging Entities in Dermatology and Dermatopathology
Call for Price Quick View Compare -
Sale!

New and Emerging Issues in Latinx Health
د.إ646.00Original price was: د.إ646.00.د.إ560.00Current price is: د.إ560.00. Quick View Compare -

New and Future Developments in Microbial Biotechnology and Bioengineering
د.إ1,293.00 Quick View Compare -
New and Future Developments in Microbial Biotechnology and Bioengineering
د.إ1,352.00 Quick View Compare -

New and Future Developments in Microbial Biotechnology and Bioengineering
د.إ1,083.00 Quick View Compare -

New and Future Developments in Microbial Biotechnology and Bioengineering
د.إ780.00 Quick View Compare -
Sale!

New Approaches to Health Literacy
د.إ1,176.00Original price was: د.إ1,176.00.د.إ55.00Current price is: د.إ55.00. Quick View Compare -

New Concepts in Diagnosis and Therapy of Pancreatic Adenocarcinoma
Call for Price Quick View Compare -

New Concepts in ECG Interpretation
Call for Price Quick View Compare -

NEW DENTAL DIET FOR ADULTS AND KIDS
د.إ194.00 Quick View Compare -

New Developments in Asthma Research
Call for Price Quick View Compare -
Sale!

New Developments in Blood Transfusion Research
د.إ912.00Original price was: د.إ912.00.د.إ300.00Current price is: د.إ300.00. Quick View Compare -

New Developments in Mechanical Ventilation
Call for Price Quick View Compare
Recently Viewed Products
No recently viewed products to display

